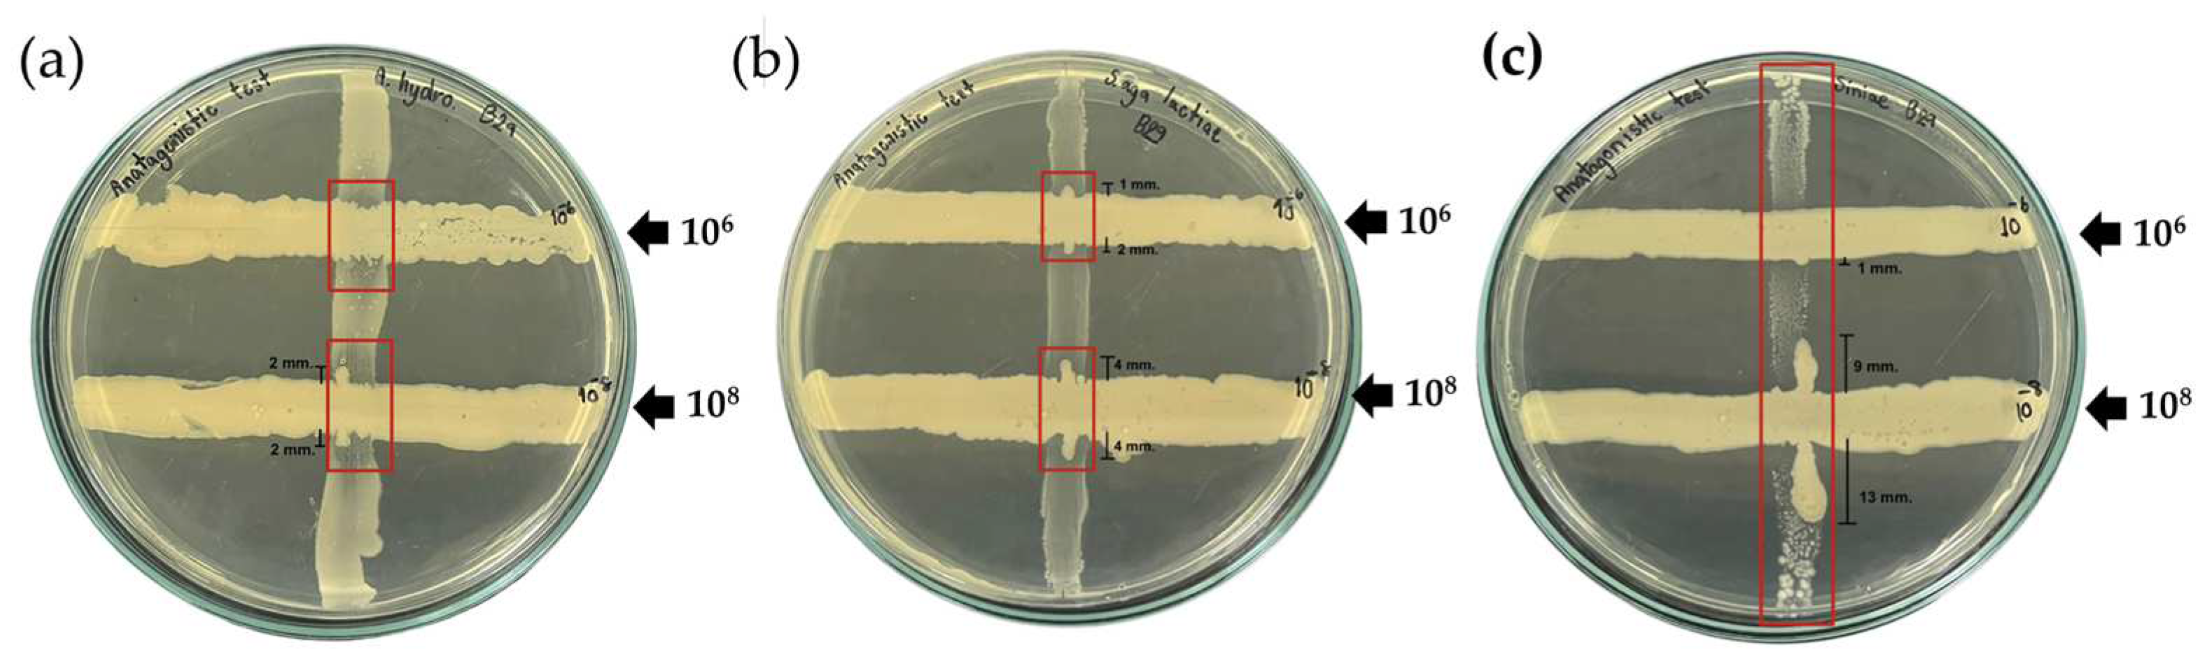
Animals 13 00986 g001
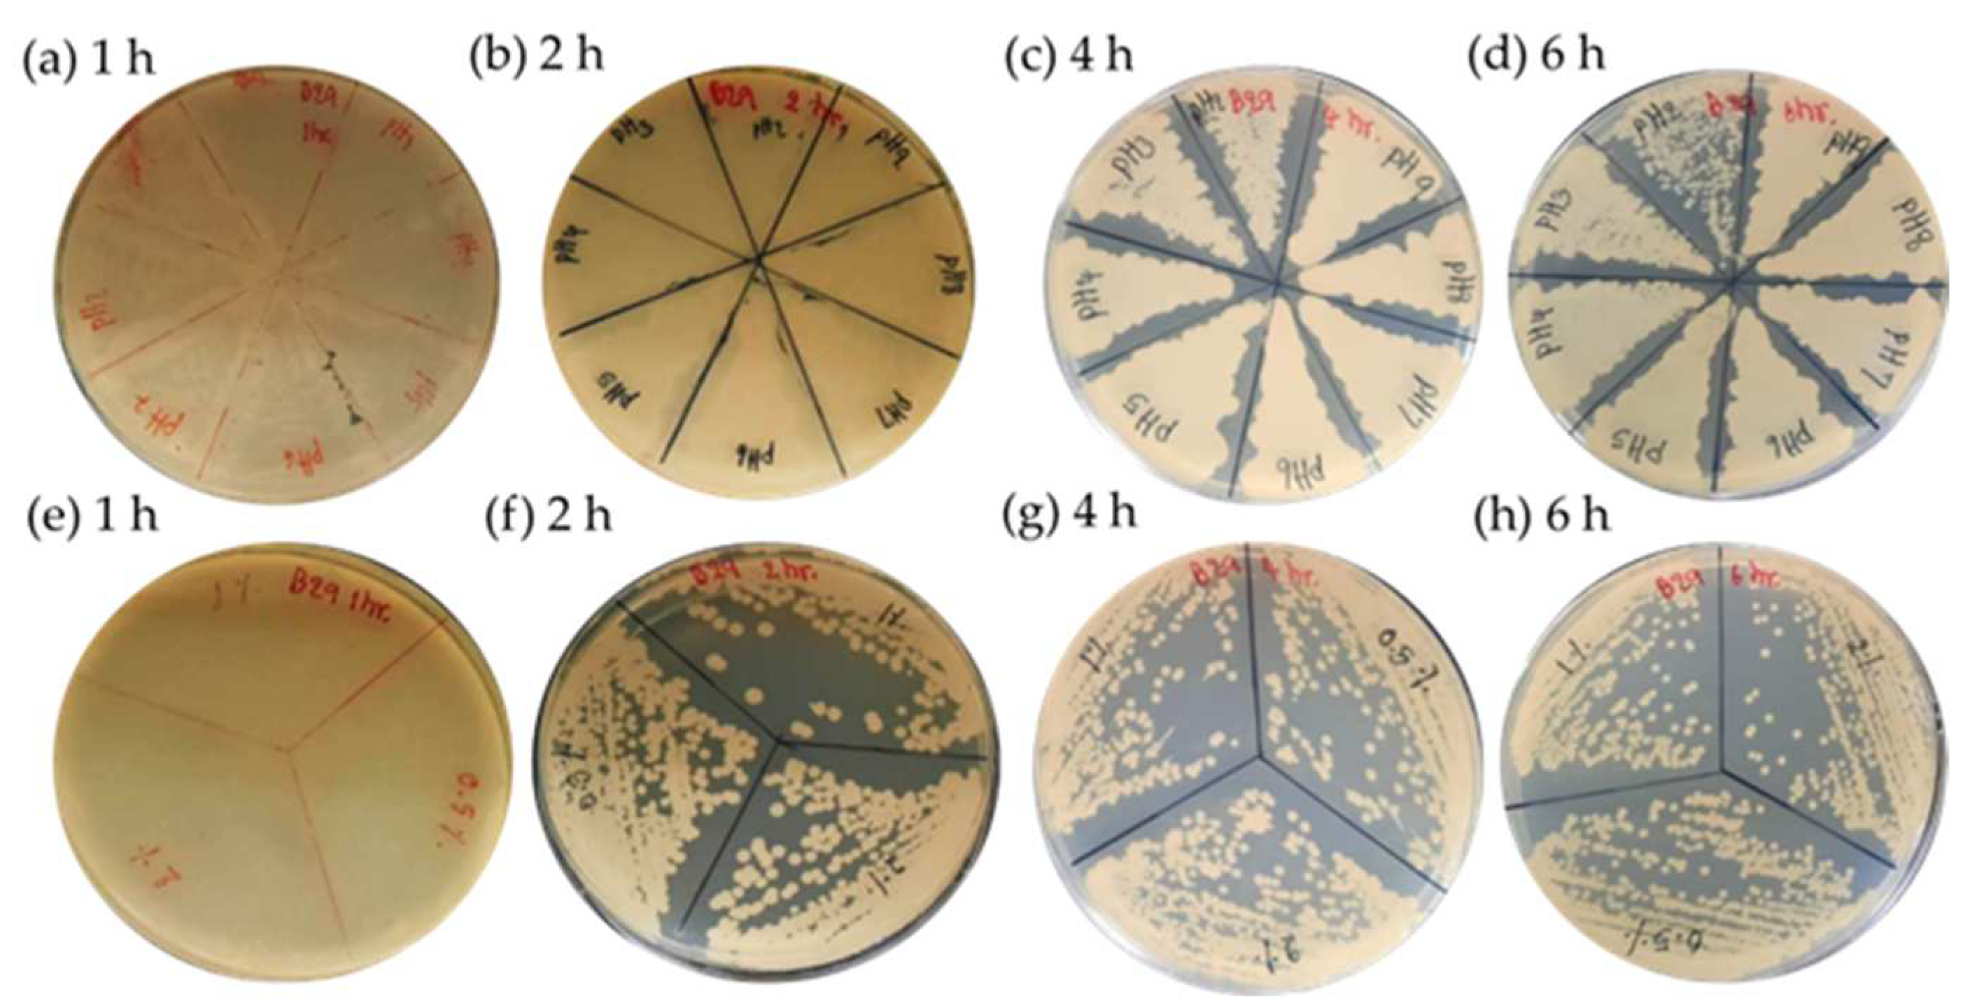
Animals 13 00986 g003

Isolation of Potential Probiotic Bacillus spp. from the Intestine of Nile Tilapia to Construct Recombinant Probiotic Expressing CC Chemokine and Its Effectiveness on Innate Immune Responses in Nile Tilapia
Abstract
Simple Summary
Abstract
1. Introduction
2. Materials and Methods
2.1. Isolation of Potential Probiotic Bacillus spp.
2.1.1. Experimental Animals
2.1.2. Bacterial Isolation and Characterization
2.1.3. Antagonistic Activity against Pathogenic Bacteria
2.1.4. Phylogenetic Analysis
2.1.5. Determination of Bile Salts Tolerance
2.1.6. Determination of pH Resistance
2.1.7. Antibiotic Susceptibility
2.1.8. Determination of Protease-Producing Capacity
2.1.9. Safety and Pathogenicity Assessments
2.2. Construction of Recombinant Probiotic Bacillus Isolate B29 Expressing CC Chemokine
2.3. Western Blot Analysis
2.4. Effects of Dietary Probiotic Supplementation on Gene Expression and Innate Immune Response
2.4.1. Experimental Design
2.4.2. Diet Preparation
2.4.3. Fish Sampling and Collection
2.4.4. Expression Level Analysis of CC Chemokine mRNA of Nile Tilapia after Feeding with Experimental Diets Using Real-Time Quantitative PCR
Gene Cloning
Total RNA Extraction and qRT-PCR Analysis
2.4.5. Immune Assays
Lysozyme Activity
Total Immunoglobulin (Ig)
Alternative Complement (ACH50) Activity
Phagocytic Activity Analysis
2.5. Statistical Analysis
3. Results
3.1. Bacterial Isolation and Characterization
3.2. Antagonistic Activity against Pathogenic Bacteria
3.3. Phylogenetic Analysis
3.4. pH and Bile Salts Tolerance Test
3.5. Protease-Producing Capacity
3.6. Antimicrobial Susceptibility Profile
3.7. Safety of Candidate Strains to Nile Tilapia
3.8. Production of Recombinant Probiotic Expressing CC Chemokine in Nile Tilapia and Western Blot Analysis
3.9. Expression Level Analysis of CC Chemokine mRNA of Nile Tilapia after Feeding with Experimental Diets Using Real-Time Quantitative PCR
3.10. Effects of Wild-Type and Recombinant Probiotic Supplemented Feed on Innate Immune Responses of Nile Tilapia
4. Discussion
5. Conclusions
Author Contributions
Funding
Institutional Review Board Statement
Informed Consent Statement
Data Availability Statement
Acknowledgments
Conflicts of Interest
References
- Thailand GLOBEFISH Market Profile—2018. Available online: https://www.fao.org/3/cb5866en/cb5866en.pdf (accessed on 2 February 2023).
- Panigrahi, A.; Kiron, V.; Kobayashi, T.; Puangkaew, J.; Satoh, S.; Sugita, H. Immune responses in rainbow trout Oncorhynchus mykiss induced by a potential probiotic bacteria Lactobacillus rhamnosus JCM 1136. Vet. Immunol. Immunopathol. 2004, 102, 379–388. [Google Scholar] [CrossRef]
- Martínez Cruz, P.; Ibáñez, A.L.; Monroy Hermosillo, O.A.; Ramírez Saad, H.C. Use of probiotics in aquaculture. ISRN Microbiol. 2012, 2012, 1–13. [Google Scholar] [CrossRef] [PubMed]
- Pereira, W.A.; Mendonça, C.M.N.; Urquiza, A.V.; Marteinsson, V.Þ.; LeBlanc, J.G.; Cotter, P.D.; Villalobos, E.F.; Romero, J.; Oliveira, R.P.S. Use of Probiotic Bacteria and Bacteriocins as an Alternative to Antibiotics in Aquaculture. Microorganisms 2022, 10, 1705. [Google Scholar] [CrossRef] [PubMed]
- Plaza-Diaz, J.; Ruiz-Ojeda, F.J.; Gil-Campos, M.; Gil, A. Mechanisms of Action of Probiotics. Adv. Nutr. 2019, 10, S49–S66. [Google Scholar] [CrossRef] [PubMed]
- Nayak, S.K. Probiotics and immunity: A fish perspective. Fish Shellfish Immunol. 2010, 29, 2–14. [Google Scholar] [CrossRef]
- Simo´n, R.; Docando, F.; Nuñez-Ortiz, N.; Tafalla, C.; Dıaz-Rosales, P. Mechanisms Used by Probiotics to Confer Pathogen Resistance to Teleost Fish. Front. Immunol. 2021, 12, 1–19. [Google Scholar] [CrossRef]
- Arig, N.; Suzer, C.; Gökvardar, A.; Başaran, F.; Çoban, D.; Yildirim, Ş.; Kamaci, H.O.; Firat, K.; Saka, S. Effects of Probiotic (Bacillus sp.) Supplementation during Larval Development of Gilthead Sea Bream (Sparus aurata, L.). Turk. J. Fish. Aquat. Sci. 2013, 13, 407–414. [Google Scholar] [CrossRef]
- Rollo, A.; Sulpizio, R.; Nardi, M.; Silvi, S.; Orpianesi, C.; Caggiano, M.; Cresci, A.; Carnevali, O. Live microbial feed supplement in aquaculture for improvement of stress tolerance. Fish Physiol. Biochem. 2006, 32, 167–177. [Google Scholar] [CrossRef]
- Welker, T.L.; Lim, C. Use of Probiotics in Diets of Tilapia. J. Aquac. Res. Dev. 2011, S1, 1–8. [Google Scholar]
- Amenyogbe, E.; Chen, G.; Wang, Z.; Huang, J.; Huang, B.; Li, H. The exploitation of probiotics, prebiotics and synbiotics in aquaculture: Present study, limitations and future directions: A review. Aquac. Int. 2020, 28, 1017–1041. [Google Scholar] [CrossRef]
- Banerjee, G.; Ray, A.K. The advancement of probiotics research and its application in fish farming industries. Res. Vet. Sci. 2017, 115, 66–77. [Google Scholar] [CrossRef]
- Chauhan, A.; Singh, R. Probiotics in aquaculture: A promising emerging alternative approach. Symbiosis 2019, 77, 99–113. [Google Scholar] [CrossRef]
- Selim, K.M.; Reda, R.M. Improvement of immunity and disease resistance in the Nile tilapia, Oreochromis niloticus, by dietary supplementation with Bacillus amyloliquefaciens. Fish Shellfish Immunol. 2015, 44, 496–503. [Google Scholar] [CrossRef]
- Soltani, M.; Ghosh, K.; Hoseinifar, S.H.; Kumar, V.; Lymbery, A.J.; Roy, S.; Ringø, E. Genus bacillus, promising probiotics in aquaculture: Aquatic animal origin, bio-active components, bioremediation and efficacy in fish and shellfish. Rev. Fish. Sci. Aquac. 2019, 27, 1–50. [Google Scholar]
- Cutting, S.M.; Hong, H.A.; Baccigalupi, L.; Ricca, E. Oral vaccine delivery by recombinant spore probiotics. Int. Rev. Immunol. 2009, 28, 487–505. [Google Scholar] [CrossRef]
- Yang, Y.; Zhang, G.; Wu, J.; Chen, X.; Tong, D.; Yang, Y.; Shi, H.; Yao, C.; Zhuang, L.; Wang, J.; et al. Recombinant HcGAPDH Protein Expressed on Probiotic Bacillus subtilis Spores Protects Sheep from Haemonchus contortus Infection by Inducing both Humoral and Cell-Mediated Responses. mSystems. 2020, 5, 1–18. [Google Scholar] [CrossRef]
- Liu, L.; Liu, Y.; Shin, H.-D.; Chen, R.R.; Wang, N.S.; Li, J.; Du, G.; Chen, J. Developing Bacillus spp. as a cell factory for production of microbial enzymes and industrially important biochemicals in the context of systems and synthetic biology. Appl. Microb. Biotech. 2013, 97, 6113–6127. [Google Scholar] [CrossRef]
- Dong, H.; Zhang, D. Current development in genetic engineering strategies of Bacillus species. Microb. Cell Fact. 2014, 13, 1–11. [Google Scholar] [CrossRef]
- Cui, W.; Han, L.; Suo, F.; Liu, Z.; Zhou, L.; Zhou, Z. Exploitation of Bacillus subtilis as a robust workhorse for production of heterologous proteins and beyond. World J. Microbiol. Biotechnol. 2018, 34, 1–19. [Google Scholar] [CrossRef]
- Alejo, A.; Tafalla, C. Chemokines in teleost fish species. Dev. Comp. Immunol. 2011, 35, 1215–1222. [Google Scholar] [CrossRef]
- Bird, S.; Tafalla, C. Teleost Chemokines and Their Receptors. Biology 2015, 4, 756–784. [Google Scholar] [CrossRef] [PubMed]
- Viola, A.; Luster, A.D. Chemokines and their receptors: Drug targets in immunity and inflammation. Annu. Rev. Pharm. Toxicol. 2008, 48, 171–197. [Google Scholar] [CrossRef] [PubMed]
- Dixon, B.; Shum, B.; Adams, E.J.; Magor, K.E.; Hedrick, R.P.; Muir, D.G.; Parham, P. CK-1, a putative chemokine of rainbow trout (Oncorhynchus mykiss). Immunol. Rev. 1998, 166, 341–348. [Google Scholar] [CrossRef]
- Laing, K.J.; Secombes, C.J. Trout CC chemokines: Comparison of their sequences and expression patterns. Mol. Immunol. 2004, 41, 793–804. [Google Scholar] [CrossRef] [PubMed]
- Bao, B.; Peatman, E.; Peng, X.; Baoprasertkul, P.; Wang, G.; Liu, Z. Characterization of 23 CC chemokine genes and analysis of their expression in channel catfish (Ictalurus punctatus). Dev. Comp. Immunol. 2006, 30, 783–796. [Google Scholar] [CrossRef]
- Nomiyama, H.; Hieshima, K.; Osada, N.; Kato-Unoki, Y.; Otsuka-Ono, K.; Takegawa, S.; Izawa, T.; Yoshizawa, A.; Kikuchi, Y.; Tanase, S.; et al. Extensive expansion and diversification of the chemokine gene family in zebrafish: Identification of a novel chemokine subfamily CX. BMC Genom. 2008, 9, 222. [Google Scholar] [CrossRef]
- Zhang, J.; Chen, X. Molecular characterization of a novel CC chemokine in large yellow croaker (Pseudosciaena crocea) and its involvement in modulation of MHC class I antigen processing and presentation pathway. Mol. Immunol. 2008, 45, 2076–2086. [Google Scholar] [CrossRef]
- Kim, J.W.; Kim, E.G.; Kim, D.H.; Shim, S.H.; Park, C.I. Molecular identification and expression analysis of the CC chemokine gene in rock bream (Oplegnathus fasciatus) and the biological activity of the recombinant protein. Fish Shellfish Immunol. 2013, 34, 892–901. [Google Scholar] [CrossRef]
- Bhatt, P.; Kumaresan, V.; Palanisamy, R.; Chaurasia, M.K.; Gnanam, A.J.; Pasupuleti, M.; Arockiaraj, J. Immunological role of C4 CC chemokine-1 from snakehead murrel Channa striatus. Mol. Immunol. 2014, 57, 292–301. [Google Scholar] [CrossRef]
- Nakharuthai, C.; Areechon, N.; Srisapoome, P. Molecular characterization, functional analysis, and defense mechanisms of two CC chemokines in Nile tilapia (Oreochromis niloticus) in response to severely pathogenic bacteria. Dev. Comp. Immunol. 2016, 59, 207–228. [Google Scholar] [CrossRef]
- Kim, J.Y.; Park, J.S.; Jung, T.S.; Kim, H.J.; Kwon, S.R. Molecular cloning and characterization of chemokine C–C motif ligand 34 (CCL34) genes from olive flounder (Paralichthys olivaceus). Fish Shellfish Immunol. 2021, 116, 42–51. [Google Scholar] [CrossRef] [PubMed]
- de Lillo, A.; Ashley, F.P.; Palmer, R.M.; Munson, M.A.; Kyriacou, L.; Weightman, A.J.; Wade, W.G. Novel subgingival bacterial phylotypes detected using multiple universal polymerase chain reaction primer sets. Oral Microbiol. Immunol. 2006, 21, 61–68. [Google Scholar] [CrossRef]
- Sookchaiyaporn, N.; Srisapoome, P.; Unajak, S.; Areechon, N. Efficacy of Bacillus spp. isolated from Nile tilapia Oreochromis niloticus Linn. on its growth and immunity, and control of pathogenic bacteria. Fish Sci. 2019, 86, 353–365. [Google Scholar] [CrossRef]
- Tamura, K.; Nei, M. Estimation of the number of nucleotide substitutions in the control region of mitochondrial DNA in humans and chimpanzees. Mol. Biol. Evol. 1993, 10, 512–526. [Google Scholar]
- Kumar, S.; Stecher, G.; Li, M.; Knyaz, C.; Tamura, K. MEGA X: Molecular Evolutionary Genetics Analysis across computing platforms. Mol. Biol. Evol. 2018, 35, 1547–1549. [Google Scholar] [CrossRef]
- Heatley, N.G. A method for the assay of penicillin. Biochem. J. 1944, 38, 61–65. [Google Scholar] [CrossRef]
- National Committee for Clinical Laboratory Standards. Performance Standards for Antimicrobial Disk Susceptibility Tests; National Committee for Clinical Laboratory Standards: Villanova, PA, USA, 1997. [Google Scholar]
- Xue, G.P.; Johnson, J.S.; Dalrymple, B.P. High osmolarity improves the electro-transformation efficiency of the gram-positive bacteria Bacillus subtilis and Bacillus licheniformis. J. Microbiol. Methods 1999, 34, 183–191. [Google Scholar] [CrossRef]
- Boonanuntanasarn, S.; Nakharuthai, C.; Schrama, D.; Duangkaewa, R.; Rodrigues, P.M. Effects of dietary lipid sources on hepatic nutritive contents, fatty acid composition and proteome of Nile tilapia (Oreochromis niloticus). J. Proteom. 2019, 192, 208–222. [Google Scholar] [CrossRef]
- Siwicki, A.K.; Studnicka, M. The phagocytic activity of neutrophils and serum lysozyme activity in experimentally infected carp, Cyprinus carpio L. J. Fish Biol. 1987, 31, 57–60. [Google Scholar] [CrossRef]
- Siwicki, A.K.; Anderson, D.P. Nonspecific defence mechanisms assay in fish II: Potential killing activity of neutrophils and macrophages, lysozyme activity in serum and organs and total immunoglobulin (Ig) levels in serum. In Fish Diseases Diagnosis and Prevention’s Methods; FAO-Project GCP/INT/526/JPN; IFI: Olsztyn, Poland, 1993; pp. 105–112. [Google Scholar]
- Milla, S.; Mathieu, C.; Wang, N.; Lambert, S.; Nadzialek, S.; Massart, S.; Henrotte, E.; Douxfils, J.; Mélard, C.; Mandiki, S.N.M.; et al. Spleen immune status is affected after acute handling stress but not regulated by cortisol in Eurasian perch, Perca fluviatilis. Fish Shellfish Immunol. 2010, 28, 931–941. [Google Scholar] [CrossRef] [PubMed]
- Puangkaew, J.; Kiron, V.; Somamoto, T.; Okamoto, N.; Satoh, S.; Takeuchi, T.; Watanabe, T. Nonspecific immune response of rainbow trout (Oncorhynchus mykiss Walbaum) in relation to different status of vitamin E and highly unsaturated fatty acids. Fish Shellfish Immunol. 2004, 16, 25–39. [Google Scholar] [CrossRef] [PubMed]
- Westers, L.; Westers, H.; Quax, W.J. Bacillus subtilis as cell factory for pharmaceutical proteins:a biotechnological approach to optimize the host organism. Biochim. Biophys. Acta Proteins Proteom. 2004, 1694, 299–310. [Google Scholar] [CrossRef]
- Su, Y.; Liu, C.; Fang, H.; Zhan, D. Bacillus subtilis: A universal cell factory for industry, agriculture, biomaterials and medicine. Microb. Cell Fact. 2020, 19, 1–12. [Google Scholar] [CrossRef]
- Truong Thy, H.T.; Nguyen, N.T.; Ong, M.Q.; Kannika, K.; Unajak, S.; Areechon, N. Effects of the dietary supplementation of mixed probiotic spores of Bacillus amyloliquefaciens 54A, and Bacillus pumilus 47B on growth, innate immunity and stress responses of striped catfish (Pangasianodon hypophthalmus). Fish Shellfish Immunol. 2017, 60, 391–399. [Google Scholar] [CrossRef] [PubMed]
- Ghosh, K.; Sukanta, K.S.; Arun, K.R. Supplementation of an isolated fish gut bacterium, Bacillus circulans, in formulated diets for rohu, Labeo rohita, fingerlings. Isr. J. Aquac. 2003, 55, 13–21. [Google Scholar] [CrossRef]
- Parvathi, K.; Jayaprakash, S. Evaluation of isolated gut probiotic Bacillus subtilis on Haematological parameters of Indian major carp Labeo rohita (Hamilton, 1822). Int. J. Adv. Sci. Technol. 2019, 28, 473–482. [Google Scholar]
- Meidong, R.; Khotchanalekha, K.; Doolgindachbaporn, S.; Nagasawa, T.; Nakao, M.; Sakai, K.; Tongpim, S. Evaluation of probiotic Bacillus aerius B81e isolated from healthy hybrid catfish on growth, disease resistance and innate immunity of Plamong Pangasius bocourti. Fish Shellfish Immunol. 2018, 73, 1–10. [Google Scholar] [CrossRef]
- Adorian, T.J.; Jamali, H.; Farsani, H.G.; Darvishi, P.; Hasanpour, S.; Bagheri, T.; Roozbehfar, R. Effects of probiotic bacteria Bacillus on growth performance, digestive enzyme activity, and hematological parameters of Asian sea bass, Lates calcarifer (Bloch). Probiotics Antimicrob. Proteins 2019, 11, 248–255. [Google Scholar] [CrossRef]
- Gobi, N.; Vaseeharan, B.; Chen, J.C.; Rekha, R.; Vijayakumar, S.; Anjugam, M.; Iswarya, A. Dietary supplementation of probiotic Bacillus licheniformis Dahb1 improves growth performance, mucus and serum immune parameters, antioxidant enzyme activity as well as resistance against Aeromonas hydrophila in tilapia Oreochromis mossambicus. Fish Shellfish Immunol. 2018, 74, 501–508. [Google Scholar] [CrossRef]
- Ghosh, S.; Archana, S.; Chittaranjan, S. Effect of probiotic on reproductive performance in female livebearing ornamental fish. Aquac. Res. 2007, 38, 518–526. [Google Scholar] [CrossRef]
- Cha, J.; Rahimnejad, S.; Yang, S.Y.; Kim, K.W.; Lee, K.J. Evaluations of Bacillus spp. as dietary additives on growth performance, innate immunity and disease resistance of olive flounder (Paralichthys olivaceus) against Streptococcus iniae and as water additives. Aquaculture 2013, 402, 50–57. [Google Scholar] [CrossRef]
- Geng, X.; Dong, X.H.; Tan, B.P.; Yang, Q.H.; Chi, S.Y.; Liu, H.Y.; Liu, X.Q. Effects of dietary probiotic on the growth performance, non-specific immunity and disease resistance of cobia, Rachycentron canadum. Aquac. Nutr. 2012, 18, 46–55. [Google Scholar] [CrossRef]
- Xue, M.; Wen, C.; Liang, H.; Ding, M.; Wu, Y.; Li, X. In vivo evaluation of the effects of commercial Bacillus probiotics on survival and development of Litopenaeus vannamei larvae during the early hatchery period. Aquac. Res. 2016, 47, 1661–1669. [Google Scholar] [CrossRef]
- Prabhurajeshwar, C.; Chandrakanth, R.K. Probiotic potential of Lactobacilli with antagonistic activity against pathogenic strains: An in vitro validation for the production of inhibitory substances. Biomed. J. 2017, 40, 270–283. [Google Scholar] [CrossRef]
- Choi, A.R.; Patra, J.K.; Kim, W.J.; Kang, S.S. Antagonistic Activities and Probiotic Potential of Lactic Acid Bacteria Derived from a Plant-Based Fermented Food. Front. Microbiol. 2018, 9, 1–12. [Google Scholar] [CrossRef] [PubMed]
- Hong, H.A.; Ducle, H.; Cutting, S.M. The use of bacterial spore formers as probiotics. FEMS Microbiol. Rev. 2005, 29, 813–835. [Google Scholar] [CrossRef]
- Zokaeifar, H.; Balca´zar, J.L.; Kamarudin, M.S.; Sijam, K.; Arshad, A.; Saad, C.R. Selection and identification of non-pathogenic bacteria isolated from fermented pickles with antagonistic properties against two shrimp pathogens. J. Antibiot. Res. 2012, 65, 289–294. [Google Scholar] [CrossRef]
- Liu, X.F.; Li, Y.; Li, J.R.; Cai, L.Y.; Li, X.X.; Chen, J.R.; Lyu, S.X. Isolation and characterisation of Bacillus spp. antagonistic to Vibrio parahaemolyticus for use as probiotics in aquaculture. World J. Microbiol. Biotechnol. 2015, 31, 795–803. [Google Scholar] [CrossRef]
- Vaseeharan, B.; Ramasamy, P. Control of pathogenic Vibrio spp. by Bacillus subtilis BT23, a possible probiotic treatment for black tiger shrimp Penaeus monodon. Lett. Appl. Microbiol. 2003, 36, 83–87. [Google Scholar] [CrossRef]
- Chen, Y.; Li, J.; Xiao, P.; Zhu, W.; Mo, Z. The ability of marine Bacillus spp. isolated from fish gastrointestinal tract and culture pond sediment to inhibit growth of aquatic pathogenic bacteria. Iran. J. Fish. Sci. 2016, 15, 701–714. [Google Scholar]
- Balcázar, J.L.; Vendrell, D.; De Blas, I.; Ruiz-Zarzuela, I.; Muzquiz, O.; Girones, J.L. Characterization of probiotic properties of lactic acid bacteria isolated from intestinal microbiota of fish. Aquaculture 2008, 278, 188–191. [Google Scholar] [CrossRef]
- Midhun, S.J.; Neethu, S.; Vysakh, A.; Radhakrishnan, E.K.; Jyothis, M. Antagonism Against Fish Pathogens by Cellular Components/Preparations of Bacillus coagulans (MTCC-9872) and It’s In Vitro Probiotic Characterisation. Curr. Microbiol. 2018, 75, 1174–1181. [Google Scholar] [CrossRef]
- Zhu, M.L.; Wang, Y.H.; Dai, Y.; Wu, X.Q.; Ye, J.R. Effects of Different Culture Conditions on the Biofilm Formation of Bacillus pumilus HR10. Curr. Microbiol. 2020, 77, 1405–1411. [Google Scholar] [CrossRef]
- Sun, Y.Z.; Yang, H.L.; Ma, R.L.; Lin, W.Y. Probiotic applications of two dominant gut Bacillus strains with antagonistic activity improved the growth performance and immune responses of grouper Epinephelus coioides. Fish Shellfish Immunol. 2010, 29, 803–809. [Google Scholar] [CrossRef]
- Andani, H.R.R.; Tukmechi, A.; Meshkini, S.; Sheikhzadeh, N. Antagonistic activity of two potential probiotic bacteria from fish intestines and investigation of their effects on growth performance and immune response in rainbow trout (Oncorhynchus mykiss). J. Appl. Ichthyol. 2012, 28, 728–734. [Google Scholar] [CrossRef]
- Zang, L.X.; Ma, Y.; Huang, W.H.; Ling, Y.H.; Sun, L.M.; Wang, X.D.; Zeng, A.B.; Danlgren, R.A.; Wang, C.H.; Wang, H.L. Dietary Lactobacillus plantarum ST-III alleviates the toxic effects of triclosan on zebrafish (Danio rerio) via gut microbiota modulation. Fish Shellfish Immunol. 2019, 84, 1157–1169. [Google Scholar] [CrossRef]
- Li, X.; Huang, Z.; Liu, H.; Wang, X.; Chen, J.; Dai, L.; Dong, S.; Xiao, Y.; Yang, L.; Liu, W. Screening of antagonistic bacteria against Flavobacterium columnus and its effects on growth performance and immune function of Carassius auratus. Reprod. Breed. 2022, 2, 138–148. [Google Scholar] [CrossRef]
- Ripert, G.; Racedo, S.M.; Elie, A.M.; Jacquot, C.; Bressollier, P.; Urdaci, M.C. Secreted Compounds of the Probiotic Bacillus clausii Strain O/C Inhibit the Cytotoxic Effects Induced by Clostridium difficile and Bacillus cereus Toxins. Antimicrob. Agents Chemother. 2016, 60, 3445–3454. [Google Scholar] [CrossRef]
- Wei, Y.; Bu, J.; Long, H.; Zhang, X.; Cai, X.; Huang, A.; Ren, W.; Xie, Z. Community Structure of Protease-Producing Bacteria Cultivated from Aquaculture Systems: Potential Impact of a Tropical Environment. Front. Microbiol. 2021, 12, 1–11. [Google Scholar] [CrossRef]
- Sun, Y.; Wen, Z.; Li, X.; Meng, N.; Mi, R.; Li, Y.; Li, S. Dietary supplement of fructooligosaccharides and Bacillus subtilis enhances the growth rate and disease resistance of the sea cucumber Apostichopus japonicus (Selenka). Aquac. Res. 2012, 43, 1328–1334. [Google Scholar] [CrossRef]
- Liu, C.H.; Chiu, C.H.; Wang, S.W.; Cheng, W. Dietary administration of the probiotic, Bacillus subtilis E20, enhances the growth, innate immune responses, and disease resistance of the grouper, Epinephelus coioides. Fish Shellfish Immunol. 2012, 33, 699–706. [Google Scholar] [CrossRef] [PubMed]
- Janeway, C.A.; Medzhitov, R. Innate immune recognition. Annu. Rev. Immunol. 2002, 20, 197–216. [Google Scholar] [CrossRef] [PubMed]
- Agbede, S.A.; Adedeji, O.B.; Adeyemo, O.K. Tissues and organs involved in the non-specific defence mechanism in fish. J. Appl. Sci. Res. 2012, 8, 2493–2496. [Google Scholar]
- Trede, N.S.; Langenau, D.M.; Traver, D.; Look, A.T.; Zon, L.I. The use of zebrafish to understand immunity. Immunity 2004, 20, 367–379. [Google Scholar] [CrossRef]
- Magnadóttir, B. Innate immunity of fish. Fish Shellfish Immun. 2006, 20, 137–151. [Google Scholar] [CrossRef]
- Li, L.; Cardoso, J.C.R.; Félix, R.C.; Mateus, A.P.; Canário, A.V.M.; Power, D.M. Fish lysozyme gene family evolution and divergent function in early development. Dev. Comp. Immunol. 2021, 114, 1–19. [Google Scholar] [CrossRef]
- Castanho, S.; Califano, G.; Soares, F.; Costa, R.; Mata, L.; Pousao-Ferreira, P.; Ribeiro, L. The effect of live feeds bathed with the red seaweed Asparagopsis armata on the survival, growth and physiology status of Sparus aurata larvae. Fish Physiol. Biochem. 2017, 43, 1043–1054. [Google Scholar] [CrossRef]
- Cecchini, S.; Terova, G.; Caricato, G.; Saroglia, M. Lysozyme activity in embryos and larvae of sea bass (Dicentrarchus labrax L.), spawned by broodstocks fed with vitamin C enriched diets. Bull. Eur. Assoc. Fish Pathol. 2000, 20, 120–124. [Google Scholar]
- Saurabh, S.; Sahoo, P.K. Lysozyme: An important defence molecule of fish innate immune system. Aquacult. Res. 2008, 39, 223–239. [Google Scholar] [CrossRef]
- Pieper, K.; Grimbacher, B.; Eibel, H. B-cell biology and development. J. Allergy Clin. Immunol. 2013, 131, 959–971. [Google Scholar] [CrossRef]
- Bonecchi, R.; Galliera, E.; Borroni, E.M.; Corsi, M.M.; Locati, M.; Mantovani, A. Chemokines and chemokine receptors: An overview. Front Biosci. 2009, 14, 540–551. [Google Scholar] [CrossRef] [PubMed]
- Sommer, F.; Torraca, V.; Meijer, A.H. Chemokine Receptors and Phagocyte Biology in Zebrafish. Front. Immunol. 2020, 11, 1–14. [Google Scholar] [CrossRef] [PubMed]
- Kono, T.; Riichi, K.; Kawahara, E.; Masahiro, S. The analysis of immune responses of a novel CC-chemokine gene from Japanese flounder Paralichthys olivaceus. Vaccine 2003, 21, 446–457. [Google Scholar] [CrossRef]
- Esche, C.; Stellato, C.; Beck, L.A. Chemokines: Key players in innate and adaptive immunity. J. Investig. Dermatol. 2005, 125, 615–628. [Google Scholar] [CrossRef]
- Fernandez, E.J.; Lolis, E. Structure, function, and inhibition of chemokines. Annu. Rev. Pharmacol. Toxicol. 2002, 42, 469–499. [Google Scholar] [CrossRef]
- Thelen, M. Dancing to the tune of chemokines. Nat. Immunol. 2001, 2, 129–134. [Google Scholar] [CrossRef]

| Primer Name | 5′ to 3′ Nucleotide Sequences | Purposes |
|---|---|---|
| 27F | AGAGTTTGATCMTGGCTCAG | Nucleotide sequencing |
| 1492R | TACGGYTACCTTGTTACGACTT | Nucleotide sequencing |
| H-B-OnCCF | AAGCTTGGATCCTCTGGATCAGATGAAAAACT | Cloning |
| H-X-OnCCR | AAGCTTCTCGAGCTCGTTCCTGCTTTCTGAAA | Cloning |
| Beta-actinF | ACAGGATGCAGAAGGAGATCACAG | qRT-PCR |
| Beta-actinR | GTACTCCTGCTTGCTGATCCACAT | qRT-PCR |
| OnCCF | TGGGTTCGTGCCACGATTGTTGCA | qRT-PCR |
| OnCCR | TGAAGGAGAGGCGGTGGATGTTAT | qRT-PCR |
| Isolate | Gram’s Stain | Shape | Catalase Test | Species as Identified by Blast N | Accession No. | Percent Identity (%) |
|---|---|---|---|---|---|---|
| B14 | Positive | Bacilli | Positive | Lysinibacillus fusiformis strain BN-4 | JN039176.1 | 76.85 |
| B18 | Positive | Bacilli | Positive | Bacillus subtilis strain MBF4 | AB872006.1 | 81.78 |
| B19 | Positive | Bacilli | Positive | Bacillus pumilus strain CMF1C | KF640223.1 | 75.65 |
| B20 | Positive | Bacilli | Positive | Bacillus safensis strain Bs16 | JN699024.1 | 76.38 |
| B21 | Positive | Bacilli | Positive | Bacillus sp. ZK10 | KJ191434.1 | 96.08 |
| B22 | Positive | Bacilli | Positive | Bacillus pumilus strain IP5 | KY621522.1 | 96.66 |
| B23 | Positive | Bacilli | Positive | Bacillus sp. CRRI-56 | JN592473.1 | 97.24 |
| B24 | Positive | Bacilli | Positive | Bacillus sp. strain SZ170 | KU986705.1 | 98.65 |
| B27 | Positive | Bacilli | Positive | Bacillus pumilus strain K26 | KU922444.1 | 98.67 |
| B28 | Positive | Bacilli | Positive | Bacillus pumilus strain 2.1 | EF523475.1 | 99.87 |
| B29 | Positive | Bacilli | Positive | Bacillus subtilis strain WSE-KSU303 | AY887082.1 | 99.31 |
| B30 | Positive | Bacilli | Positive | Bacillus pumilus strain HNS75 | EF491624.1 | 99.87 |
| B31 | Positive | Bacilli | Positive | Bacillus stratosphericus strain B89 | LN890265.1 | 97.93 |
| Isolate | Diameter of Clear Zone (mm) |
|---|---|
| B28 | No clear zone |
| B29 | 5.00 ± 0.00 |
| B30 | 4.67 ± 0.58 |
| B31 | 4.67 ± 0.58 |
| Days Post Feeding | Treatment | ||
|---|---|---|---|
| Control | Wild-Type | Recombinant Probiotic | |
| 1 | 0.48 ± 0.03 a | 0.45 ± 0.03 a | 0.55 ± 0.04 b |
| 2 | 0.39 ± 0.05 a | 0.46 ± 0.06 ab | 0.54 ± 0.01 b |
| 7 | 0.42 ± 0.01 a | 0.43 ± 0.03 a | 0.49 ± 0.01 b |
| 15 | 0.42 ± 0.02 a | 0.44 ± 0.02 ab | 0.47 ± 0.02 b |
| 30 | 0.48 ± 0.03 a | 0.54 ± 0.04 ab | 0.59 ± 0.04 b |
Disclaimer/Publisher’s Note: The statements, opinions and data contained in all publications are solely those of the individual author(s) and contributor(s) and not of MDPI and/or the editor(s). MDPI and/or the editor(s) disclaim responsibility for any injury to people or property resulting from any ideas, methods, instructions or products referred to in the content. |
© 2023 by the authors. Licensee MDPI, Basel, Switzerland. This article is an open access article distributed under the terms and conditions of the Creative Commons Attribution (CC BY) license (https://creativecommons.org/licenses/by/4.0/).
Share and Cite
Nakharuthai, C.; Boonanuntanasarn, S.; Kaewda, J.; Manassila, P. Isolation of Potential Probiotic Bacillus spp. from the Intestine of Nile Tilapia to Construct Recombinant Probiotic Expressing CC Chemokine and Its Effectiveness on Innate Immune Responses in Nile Tilapia. Animals 2023, 13, 986. https://doi.org/10.3390/ani13060986
Nakharuthai C, Boonanuntanasarn S, Kaewda J, Manassila P. Isolation of Potential Probiotic Bacillus spp. from the Intestine of Nile Tilapia to Construct Recombinant Probiotic Expressing CC Chemokine and Its Effectiveness on Innate Immune Responses in Nile Tilapia. Animals. 2023; 13(6):986. https://doi.org/10.3390/ani13060986
Chicago/Turabian StyleNakharuthai, Chatsirin, Surintorn Boonanuntanasarn, Jirawadee Kaewda, and Pimpisut Manassila. 2023. "Isolation of Potential Probiotic Bacillus spp. from the Intestine of Nile Tilapia to Construct Recombinant Probiotic Expressing CC Chemokine and Its Effectiveness on Innate Immune Responses in Nile Tilapia" Animals 13, no. 6: 986. https://doi.org/10.3390/ani13060986
APA StyleNakharuthai, C., Boonanuntanasarn, S., Kaewda, J., & Manassila, P. (2023). Isolation of Potential Probiotic Bacillus spp. from the Intestine of Nile Tilapia to Construct Recombinant Probiotic Expressing CC Chemokine and Its Effectiveness on Innate Immune Responses in Nile Tilapia. Animals, 13(6), 986. https://doi.org/10.3390/ani13060986

